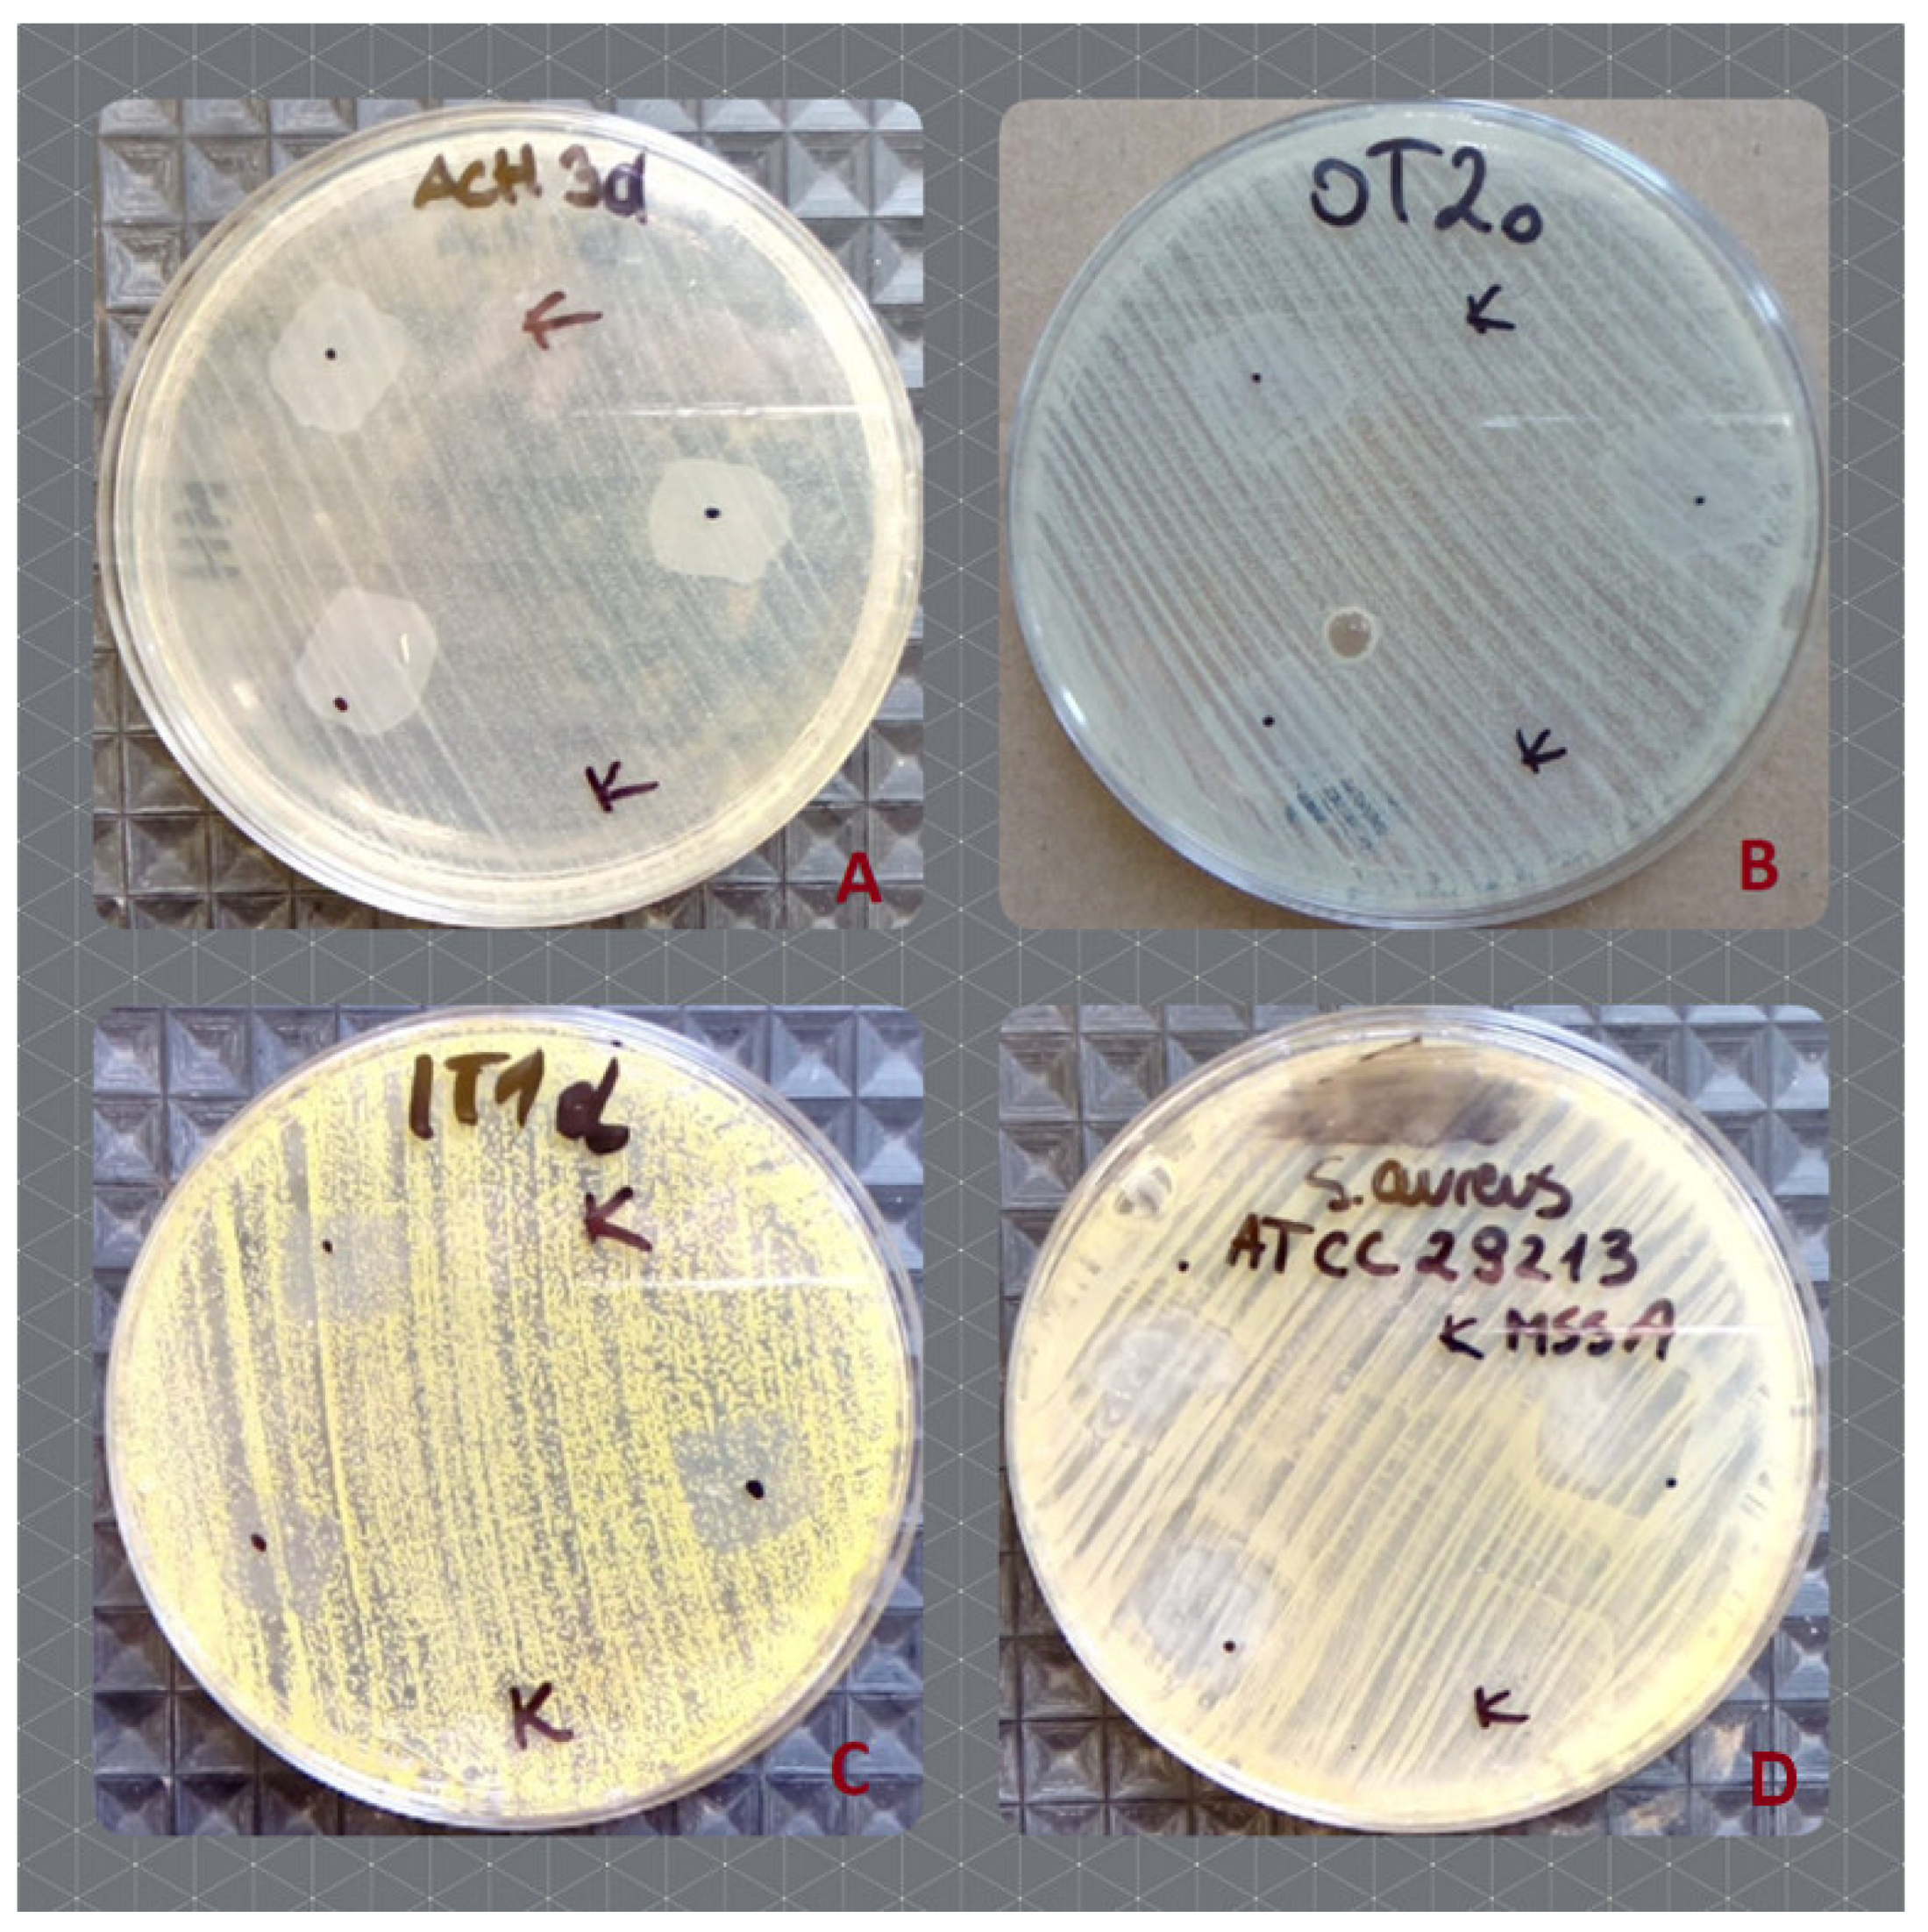
Ijms 23 14005 g006 Ijms 23 14005 g006

Preparation of Nano/Microcapsules of Ozonated Olive Oil in Hyaluronan Matrix and Analysis of Physicochemical and Microbiological (Biological) Properties of the Obtained Biocomposite
Abstract
1. Introduction
2. Results
2.1. Frequency Sweep
2.2. Analysis of the Particle Size Distribution and Particle Charge
2.3. Microbiological Analysis—The Effect of Hyal/O3 on the Microbial Growth
2.4. The Assessment of Cytotoxicity in the HaCat Keratinocyte Model
3. Discussion
4. Materials and Methods
4.1. Determination of the Ozone Content
4.2. Preparation of Ozonated Olive Oil Nanoemulsion
4.3. Hyaluronic Acid Hydrogel Preparation
4.4. Samples Preparation
4.5. SEM Microscopy
4.6. UV-VIS
4.7. FTIR-ATR
4.8. Rheological Measurements
4.9. Statistics
4.10. Dynamic Light Scattering (DLS) and Zeta Potential—Analysis of the Hydrodynamic Diameter, Polydispersity and Particle Charge
4.11. Microbiological Analysis
4.11.1. Determination of the Impact on the Microbial Growth
Isolation and Identification of the Tested Microorganisms
4.12. Antimicrobial Activity of Hyaluronic Acid with Ozone
4.13. The Assessment of Cytotoxicity
5. Conclusions
Author Contributions
Funding
Institutional Review Board Statement
Informed Consent Statement
Data Availability Statement
Conflicts of Interest
References
- Aghaei, S.; Nilforoushzadeh, M.A.; Aghaei, M. The role of peroxisome proliferator-activated receptor-coactivator-1 gene in skin aging. J. Res. Med. Sci. 2016, 21, 36. [Google Scholar] [CrossRef] [PubMed]
- Wang, M.; Luo, Y.; Wang, T.; Wan, C.; Pan, L.; Pan, S.; He, K.; Neo, A.; Chen, X. Artificial Skin Perception. Adv. Mater. 2021, 33, 2003014. [Google Scholar] [CrossRef]
- Hong, C.H.; Schachter, J.; Sutton, A.B.; Salsberg, J.M.; Li, M.K.; Humphrey, S.D.; Dayeh, N.R. 89% Vichy mineralizing water with hyaluronic acid is a well-tolerated adjunct treatment that helps restore skin barrier function in dry skin-related inflammatory dermatoses and post-procedure skin care: A Canadian study. J. Cosmet. Dermatol. 2021, 20, 2148–2155. [Google Scholar] [CrossRef] [PubMed]
- Gan, D.; Xu, T.; Xing, W.; Ge, X.; Fang, L.; Wang, K.; Ren, F.; Lu, X. Mussel-Inspired Contact-Active Antibacterial Hydrogel with High Cell Affinity, Toughness, and Recoverability. Adv. Funct. Mater. 2019, 29, 1805964. [Google Scholar] [CrossRef]
- Kim, H. Wound Dressing Materials: The Essentials. J. Wound Manag. Res. 2018, 14, 141–142. [Google Scholar] [CrossRef]
- Le, T.M.D.; Duong, H.T.T.; Thambi, T.; Giang Phan, V.H.; Jeong, J.H.; Lee, D.S. Bioinspired pH- and Temperature-Responsive Injectable Adhesive Hydrogels with Polyplexes Promotes Skin Wound Healing. Biomacromolecules 2018, 19, 3536–3548. [Google Scholar] [CrossRef]
- Priya, S.G.; Gupta, A.; Jain, E.; Sarkar, J.; Damania, A.; Jagdale, P.R.; Chaudhari, B.P.; Gupta, K.C.; Kumar, A. Bilayer Cryogel Wound Dressing and Skin Regeneration Grafts for the Treatment of Acute Skin Wounds. ACS Appl. Mater. Interfaces 2016, 8, 15145–15159. [Google Scholar] [CrossRef]
- Turabee, M.H.; Thambi, T.; Lee, D.S. Development of an Injectable Tissue Adhesive Hybrid Hydrogel for Growth Factor-Free Tissue Integration in Advanced Wound Regeneration. ACS Appl. Bio Mater. 2019, 2, 2500–2510. [Google Scholar] [CrossRef] [PubMed]
- Wan, X.; Liu, S.; Xin, X.; Li, P.; Dou, J.; Han, X.; Kang, I.K.; Yuan, J.; Chi, B.; Shen, J. S-nitrosated keratin composite mats with NO release capacity for wound healing. Chem. Eng. J. 2020, 400, 125964. [Google Scholar] [CrossRef]
- Li, Z.; Chen, Z.; Chen, H.; Chen, K.; Tao, W.; Ouyang, X.; Mei, L.; Zeng, X. Polyphenol-based hydrogels: Pyramid evolution from crosslinked structures to biomedical applications and the reverse design. Bioact. Mater. 2022, 17, 49–70. [Google Scholar] [CrossRef]
- Thiele, J.; Ma, Y.; Bruekers, S.M.C.; Ma, S.; Huck, W.T.S. 25th Anniversary Article: Designer Hydrogels for Cell Cultures: A Materials Selection Guide. Adv. Mater. 2014, 26, 125–148. [Google Scholar] [CrossRef] [PubMed]
- Yang, R.; Liu, X.; Ren, Y.; Xue, W.; Liu, S.; Wang, P.; Zhao, M.; Xu, H.; Chi, B. Injectable adaptive self-healing hyaluronic acid/poly (γ-glutamic acid) hydrogel for cutaneous wound healing. Acta Biomater. 2021, 127, 102–115. [Google Scholar] [CrossRef] [PubMed]
- Zhang, Y.S.; Khademhosseini, A. Advances in engineering hydrogels. Science 2017, 356, eaaf3627. [Google Scholar] [CrossRef]
- Juncan, A.M.; Moisă, D.G.; Santini, A.; Morgovan, C.; Rus, L.L.; Vonica-țincu, A.L.; Loghin, F. Advantages of Hyaluronic Acid and Its Combination with Other Bioactive Ingredients in Cosmeceuticals. Molecule 2021, 26, 4429. [Google Scholar] [CrossRef]
- Li, H.; Xue, Y.; Jia, B.; Bai, Y.; Zuo, Y.; Wang, S.; Zhao, Y.; Yang, W.; Tang, H. The preparation of hyaluronic acid grafted pullulan polymers and their use in the formation of novel biocompatible wound healing film. Carbohydr. Polym. 2018, 188, 92–100. [Google Scholar] [CrossRef] [PubMed]
- Snetkov, P.; Zakharova, K.; Morozkina, S.; Olekhnovich, R.; Uspenskaya, M. Hyaluronic Acid: The Influence of Molecular Weight on Structural, Physical, Physico-Chemical, and Degradable Properties of Biopolymer. Polymers 2020, 12, 1800. [Google Scholar] [CrossRef] [PubMed]
- El-Aassar, M.R.; El-Beheri, N.G.; Agwa, M.M.; Eltaher, H.M.; Alseqely, M.; Sadik, W.S.; El-Khordagui, L. Antibiotic-free combinational hyaluronic acid blend nanofibers for wound healing enhancement. Int. J. Biol. Macromol. 2021, 167, 1552–1563. [Google Scholar] [CrossRef]
- Kawano, Y.; Patrulea, V.; Sublet, E.; Borchard, G.; Iyoda, T.; Kageyama, R.; Morita, A.; Seino, S.; Yoshida, H.; Jordan, O.; et al. Wound healing promotion by hyaluronic acid: Effect of molecular weight on gene expression and in vivo wound closure. Pharmaceuticals 2021, 14, 301. [Google Scholar] [CrossRef] [PubMed]
- Ribeiro, D.M.L.; Júnior, A.R.C.; de Macedo, G.H.R.V.; Chagas, V.L.; Silva, L.D.S.; da Silva Cutrim, B.; Santos, D.M.; Soares, B.L.L.; Zagmignan, A.; de Cássia Mendonça de Miranda, R.; et al. Polysaccharide-Based Formulations for Healing of Skin-Related Wound Infections: Lessons from Animal Models and Clinical Trials. Biomolecules 2019, 10, 63. [Google Scholar] [CrossRef] [PubMed]
- Prasathkumar, M.; Sadhasivam, S. Chitosan/Hyaluronic acid/Alginate and an assorted polymers loaded with honey, plant, and marine compounds for progressive wound healing—Know-how. Int. J. Biol. Macromol. 2021, 186, 656–685. [Google Scholar] [CrossRef] [PubMed]
- Su, S.; Bedir, T.; Kalkandelen, C.; Ozan Başar, A.; Turkoğlu Şaşmazel, H.; Bulent Ustundag, C.; Sengor, M.; Gunduz, O. Coaxial and emulsion electrospinning of extracted hyaluronic acid and keratin based nanofibers for wound healing applications. Eur. Polym. J. 2021, 142, 110158. [Google Scholar] [CrossRef]
- Barańska-Rybak, W.; Antoszewska, M. Combination of hyaluronic acid fillers and personalized skincare as a perfect tool in aesthetic medicine. Dermatol. Ther. 2021, 34, e15092. [Google Scholar] [CrossRef] [PubMed]
- Kibbelaar, H.V.M.; Deblais, A.; Velikov, K.P.; Bonn, D.; Shahidzadeh, N. Stringiness of hyaluronic acid emulsions. Int. J. Cosmet. Sci. 2021, 43, 458–465. [Google Scholar] [CrossRef]
- Scarano, A.; Sbarbati, A.; Amore, R.; Iorio, E.L.; Ferraro, G.; Marchetti, M.; Amuso, D. The role of hyaluronic acid and amino acid against the aging of the human skin: A clinical and histological study. J. Cosmet. Dermatol. 2021, 20, 2296–2304. [Google Scholar] [CrossRef]
- Habibi Najafi, M.B.; Haddad Khodaparast, M.H. Efficacy of ozone to reduce microbial populations in date fruits. Food Control 2009, 20, 27–30. [Google Scholar] [CrossRef]
- La Fuente, C.I.A.; de Souza, A.T.; Tadini, C.C.; Augusto, P.E.D. Ozonation of cassava starch to produce biodegradable films. Int. J. Biol. Macromol. 2019, 141, 713–720. [Google Scholar] [CrossRef] [PubMed]
- Lubojanski, A.; Dobrzynski, M.; Nowak, N.; Rewak-Soroczynska, J.; Sztyler, K.; Zakrzewski, W.; Dobrzynski, W.; Szymonowicz, M.; Rybak, Z.; Wiglusz, K.; et al. Application of Selected Nanomaterials and Ozone in Modern Clinical Dentistry. Nanomaterials 2021, 11, 259. [Google Scholar] [CrossRef] [PubMed]
- Moraes, M.M.; Coelho, M.S.; Nascimento, W.M.; Nogales, C.G.; de Campos, F.U.F.; de Jesus Soares, A.; Frozoni, M. The antimicrobial effect of different ozone protocols applied in severe curved canals contaminated with Enterococcus faecalis: Ex vivo study. Odontology 2021, 109, 696–700. [Google Scholar] [CrossRef]
- Travagli, V.; Zanardi, I.; Valacchi, G.; Bocci, V. Ozone and ozonated oils in skin diseases: A review. Mediat. Inflamm. 2010, 2010, 610418. [Google Scholar] [CrossRef]
- Baumann, L.S. Less-known botanical cosmeceuticals. Dermatol. Ther. 2007, 20, 330–342. [Google Scholar] [CrossRef]
- Lagacé-Wiens, P.; Rubinstein, E. Adverse reactions to β-lactam antimicrobials. Expert Opin. Drug Saf. 2012, 11, 381–399. [Google Scholar] [CrossRef] [PubMed]
- Nagayoshi, M.; Fukuizumi, T.; Kitamura, C.; Yano, J.; Terashita, M.; Nishihara, T. Efficacy of ozone on survival and permeability of oral microorganisms. Oral Microbiol. Immunol. 2004, 19, 240–246. [Google Scholar] [CrossRef] [PubMed]
- Ugazio, E.; Tullio, V.; Binello, A.; Tagliapietra, S.; Dosio, F. Ozonated Oils as Antimicrobial Systems in Topical Applications. Their Characterization, Current Applications, and Advances in Improved Delivery Techniques. Molecules 2020, 25, 334. [Google Scholar] [CrossRef] [PubMed]
- Fytianos, G.; Rahdar, A.; Kyzas, G.Z. Nanomaterials in Cosmetics: Recent Updates. Nanomaterials 2020, 10, 979. [Google Scholar] [CrossRef] [PubMed]
- Nanotechnology in Cosmetics: Opportunities and Challenges | NanoEra. Available online: http://bilimseldergiler.atauni.edu.tr/system/nanoera/article/view/166 (accessed on 21 February 2022).
- Salvioni, L.; Morelli, L.; Ochoa, E.; Labra, M.; Fiandra, L.; Palugan, L.; Prosperi, D.; Colombo, M. The emerging role of nanotechnology in skincare. Adv. Colloid Interface Sci. 2021, 293, 102437. [Google Scholar] [CrossRef]
- Zhang, Y.; Xie, S.-S.; Wu, Y.-C.; Yadwade, R.; Gharpure, S.; Ankamwar, B. Nanotechnology in cosmetics pros and cons. Nano Express 2021, 2, 022003. [Google Scholar] [CrossRef]
- Pan, N.C.; Pereira, H.C.B.; da Silva, M.L.C.; Vasconcelos, A.F.D.; Celligoi, M.A.P.C. Improvement Production of Hyaluronic Acid by Streptococcus zooepidemicus in Sugarcane Molasses. Appl. Biochem. Biotechnol. 2016, 182, 276–293. [Google Scholar] [CrossRef]
- Sikora, M.; Krystyjan, M.; Tomasik, P.; Krawontka, J. Mixed pastes of starches with guar gum. Polimery 2010, 55, 582–590. [Google Scholar] [CrossRef][Green Version]
- Krystyjan, M.; Khachatryan, G.; Ciesielski, W.; Buksa, K.; Sikora, M. Preparation and characteristics of mechanical and functional properties of starch/Plantago psyllium seeds mucilage films. Starch/Staerke 2017, 69, 1700014. [Google Scholar] [CrossRef]
- Kulawik-Pióro, A.; Ptaszek, A.; Kruk, J. Effective tool for assessment of the quality of barrier creams—relationships between rheological, textural and sensory properties. Regul. Toxicol. Pharmacol. 2019, 103, 113–123. [Google Scholar] [CrossRef]
- Khachatryan, G.; Khachatryan, K.; Krystyjan, M.; Krzan, M.; Khachatryan, L. Functional properties of composites containing silver nanoparticles embedded in hyaluronan and hyaluronan-lecithin matrix. Int. J. Biol. Macromol. 2020, 149, 417–423. [Google Scholar] [CrossRef]
- Ognyanov, M.; Remoroza, C.; Schols, H.A.; Georgiev, Y.N.; Petkova, N.T.; Krystyjan, M. Structural, rheological and functional properties of galactose-rich pectic polysaccharide fraction from leek. Carbohydr. Polym. 2020, 229, 115549. [Google Scholar] [CrossRef] [PubMed]
- Nowak, N.; Grzebieniarz, W.; Khachatryan, G.; Konieczna-Molenda, A.; Krzan, M.; Khachatryan, K. Preparation of nano/microcapsules of ozonated olive oil in chitosan matrix and analysis of physicochemical and microbiological properties of the obtained films. Innov. Food Sci. Emerg. Technol. 2022, 82, 103181. [Google Scholar] [CrossRef]
- Manju, S.; Sreenivasan, K. Conjugation of curcumin onto hyaluronic acid enhances its aqueous solubility and stability. J. Colloid Interface Sci. 2011, 359, 318–325. [Google Scholar] [CrossRef] [PubMed]
- Meurens, M.; Morales, M.T.; Hourant, P.; Aparicio, R.; Baeten, V. Oil and Fat Classification by Selected Bands of Near-Infrared Spectroscopy. Appl. Spectrosc. 2000, 54, 1168–1174. [Google Scholar]
- Rohman, A.; Che Man, Y.B.; Yusof, F.M. The Use of FTIR Spectroscopy and Chemometrics for Rapid Authentication of Extra Virgin Olive Oil. J. Am. Oil Chem. Soc. 2013, 91, 207–213. [Google Scholar] [CrossRef]
- Gilbert, L.; Picard, C.; Savary, G.; Grisel, M. Rheological and textural characterization of cosmetic emulsions containing natural and synthetic polymers: Relationships between both data. Colloids Surf. A Physicochem. Eng. Asp. 2013, 421, 150–163. [Google Scholar] [CrossRef]
- Miastkowska, M.; Kulawik-Pióro, A.; Szczurek, M. Nanoemulsion Gel Formulation Optimization for Burn Wounds: Analysis of Rheological and Sensory Properties. Process 2020, 8, 1416. [Google Scholar] [CrossRef]
- Birsan, M.; Bibire, N.; Diana Panainte, A.; Silasi, O.; Antonoaea, P.; Ciurba, A.; Caterina Cristofor, A.; Wroblewska, M.; Sosnowska, K. The Influence of the Preparation Method on the Characteristics of a New Cosmetic Gel Based on Hyaluronic Acid and Matrix-Forming Polymers. Mater. Plast 1964, 57, 123–130. [Google Scholar] [CrossRef]
- Brummer, R.; Godersky, S. Rheological studies to objectify sensations occurring when cosmetic emulsions are applied to the skin. Colloids Surf. A Physicochem. Eng. Asp. 1999, 152, 89–94. [Google Scholar] [CrossRef]
- Bekker, M.; Webber, G.V.; Louw, N.R. Relating rheological measurements to primary and secondary skin feeling when mineral-based and Fischer–Tropsch wax-based cosmetic emulsions and jellies are applied to the skin. Int. J. Cosmet. Sci. 2013, 35, 354–361. [Google Scholar] [CrossRef] [PubMed]
- Martin, A.N. (Ed.) Physical Pharmacy, 4th ed.; Lea and Febiger: Philadelphia, PE, USA, 1993. [Google Scholar]
- Barnes, H.A. Rheology of emulsions—A review. Colloids Surf. A Physicochem. Eng. Asp. 1994, 91, 89–95. [Google Scholar] [CrossRef]
- Steffe, J.F. Rheological Methods in. Agric. Eng. 1996, 23, 249–250. [Google Scholar]
- Koo, G.H.; Jang, J. Surface modification of poly(lactic acid) by UV/Ozone irradiation. Fibers Polym. 2009, 9, 674–678. [Google Scholar] [CrossRef]
- Li, M.; Boggs, M.; Beebe, T.P.; Huang, C.P. Oxidation of single-walled carbon nanotubes in dilute aqueous solutions by ozone as affected by ultrasound. Carbon N. Y. 2008, 46, 466–475. [Google Scholar] [CrossRef]
- Chiang, H.L.; Huang, C.P.; Chiang, P.C. The surface characteristics of activated carbon as affected by ozone and alkaline treatment. Chemosphere 2002, 47, 257–265. [Google Scholar] [CrossRef]
- Pietrocola, G.; Ceci, M.; Preda, F.; Poggio, C.; Colombo, M. Evaluation of the antibacterial activity of a new ozonized olive oil against oral and periodontal pathogens. J. Clin. Exp. Dent. 2018, 10, e1103. [Google Scholar] [CrossRef]
- Radzimierska-Kazmierczak, M.; Smigielski, K.; Sikora, M.; Nowak, A.; Plucinska, A.; Kunicka-Styczynska, A.; Czarnecka-Chrebelska, K.H. Olive Oil with Ozone-Modified Properties and Its Application. Molecules 2021, 26, 3074. [Google Scholar] [CrossRef]
- Silva, V.; Peirone, C.; Amaral, J.S.; Capita, R.; Alonso-Calleja, C.; Marques-Magallanes, J.A.; Martins, Â.; Carvalho, Á.; Maltez, L.; Pereira, J.E.; et al. High Efficacy of Ozonated Oils on the Removal of Biofilms Produced by Methicillin-Resistant Staphylococcus aureus (MRSA) from Infected Diabetic Foot Ulcers. Molecules 2020, 25, 3601. [Google Scholar] [CrossRef] [PubMed]
- Geweely, N. A Novel Comparative Review between Chemical, Natural Essential Oils and Physical (Ozone) Conservation of Archaeological Objects against Microbial Deterioration. Geomicrobiol. J. 2022, 39, 531–540. [Google Scholar] [CrossRef]
- Tara, F.; Zand-Kargar, Z.; Rajabi, O.; Berenji, F.; Akhlaghi, F.; Shakeri, M.T.; Azizi, H. The Effects of Ozonated Olive Oil and Clotrimazole Cream for Treatment of Vulvovaginal Candidiasis. Altern. Ther. Health Med. 2016, 22, 44–49. [Google Scholar] [CrossRef] [PubMed]
- Bouzid, D.; Merzouki, S.; Boukhebti, H.; Zerroug, M.M. Various Antimicrobial Agent of Ozonized Olive Oil. Ozone Sci. Eng. 2021, 43, 606–612. [Google Scholar] [CrossRef]
- Monzillo, V.; Lallitto, F.; Russo, A.; Poggio, C.; Scribante, A.; Arciola, C.R.; Bertuccio, F.R.; Colombo, M. Ozonized Gel Against Four Candida Species: A Pilot Study and Clinical Perspectives. Materials 2020, 13, 1731. [Google Scholar] [CrossRef] [PubMed]
- Nocuń, M.; Krzyściak, P.; Niedźwiedzka, E.; Niedźwiedzki, J.; Krzyściak-Kosińska, R. Aktywność ozonowanej oliwy z oliwek przy zwalczaniu drobnoustrojów. Mater. Ceram. 2018, 70, 356–370. [Google Scholar]
- Zakrzewski, W.; Dobrzynski, M.; Nowicka, J.; Pajaczkowska, M.; Szymonowicz, M.; Targonska, S.; Sobierajska, P.; Wiglusz, K.; Dobrzynski, W.; Lubojanski, A.; et al. The Influence of Ozonated Olive Oil-Loaded and Copper-Doped Nanohydroxyapatites on Planktonic Forms of Microorganisms. Nanomaterials 2020, 10, 1997. [Google Scholar] [CrossRef]
- Serio, F.; Pizzolante, G.; Cozzolino, G.; D’Alba, M.; Bagordo, F.; De Giorgi, M.; Grassi, T.; Idolo, A.; Guido, M.; De Donno, A. A New Formulation Based on Ozonated Sunflower Seed Oil: In Vitro Antibacterial and Safety Evaluation. J. Int. Ozone Assoc. 2017, 39, 139–147. [Google Scholar] [CrossRef]
- Garcia-Rubio, R.; de Oliveira, H.C.; Rivera, J.; Trevijano-Contador, N. The Fungal Cell Wall: Candida, Cryptococcus, and Aspergillus Species. Front. Microbiol. 2020, 10, 2993. [Google Scholar] [CrossRef] [PubMed]
- Delcour, A.H. Outer membrane permeability and antibiotic resistance. Biochim. Biophys. Acta—Proteins Proteom. 2009, 1794, 808–816. [Google Scholar] [CrossRef]
- Ogston, A.G.; Sherman, T.F. Effects of hyaluronic acid upon diffusion of solutes and flow of solvent. J. Physiol. 1961, 156, 67. [Google Scholar] [CrossRef]
- Kodavaty, J.; Deshpande, A.P. Evaluation of solute diffusion and polymer relaxation in cross-linked hyaluronic acid hydrogels: Experimental measurement and relaxation modeling. Polym. Bull. 2020, 78, 2605–2626. [Google Scholar] [CrossRef]
- McCabe, M.; Laurent, T.C. Diffusion of oxygen, nitrogen and water in hyaluronate solutions. Biochim. Biophys. Acta—Gen. Subj. 1975, 399, 131–138. [Google Scholar] [CrossRef]
- Guo, X.; Huang, S.; Sun, J.; Wang, F. Comparison of the Cytotoxicities and Wound Healing Effects of Hyaluronan, Carbomer, and Alginate on Skin Cells in Vitro. Adv. Ski. Wound Care 2015, 28, 410–414. [Google Scholar] [CrossRef] [PubMed]
- Zerbinati, N.; Sommatis, S.; Maccario, C.; Capillo, M.C.; Di Francesco, S.; Rauso, R.; Protasoni, M.; D’Este, E.; Gasperina, D.D.; Mocchi, R. In Vitro Evaluation of the Effect of a Not Cross-Linked Hyaluronic Acid Hydrogel on Human Keratinocytes for Mesotherapy. Gels 2021, 7, 15. [Google Scholar] [CrossRef] [PubMed]
- Bourguignon, L.Y.W.; Ramez, M.; Gilad, E.; Singleton, P.A.; Man, M.Q.; Crumrine, D.A.; Elias, P.M.; Feingold, K.R. Hyaluronan–CD44 Interaction Stimulates Keratinocyte Differentiation, Lamellar Body Formation/Secretion, and Permeability Barrier Homeostasis. J. Investig. Dermatol. 2006, 126, 1356–1365. [Google Scholar] [CrossRef] [PubMed]
- Chen, W.Y.J. Functions of Hyaluronan in Wound Repair. Hyaluronan 2002, 2, 147–156. [Google Scholar] [CrossRef]
- Sneath, R.J.S.; Mangham, D.C. The normal structure and function of CD44 and its role in neoplasia. Mol. Pathol. 1998, 51, 191. [Google Scholar] [CrossRef] [PubMed]
- Zerillo, L.; Polvere, I.; Varricchio, R.; Madera, J.R.; D’Andrea, S.; Voccola, S.; Franchini, I.; Stilo, R.; Vito, P.; Zotti, T. Antibiofilm and repair activity of ozonated oil in liposome. Microb. Biotechnol. 2022, 15, 1422–1433. [Google Scholar] [CrossRef]
- European Pharmacopoeia (Ph Eur.) 10th Edition | EDQM—European Directorate for the Quality of Medicines. Available online: https://www.edqm.eu/en/european-pharmacopoeia-ph-eur-10th-edition (accessed on 22 January 2022).

| Sample | Day of Measurement | Herschel–Bulkley Model | Area of Histeresis (Pa/s) | |||
|---|---|---|---|---|---|---|
| K (Pa/sn) | n (−) | τ0 (Pa) | R2 | |||
| Hyal | 1 | 6.88 ± 0.17 a | 0.42 ± 0.00 b | 3.21 ± 0.15 a | 0.9950 | 531.15 ± 52.68 a |
| Hyal | 15 | 5.59 ± 0.25 bc | 0.47 ± 0.04 ab | 2.13 ± 0.20 c | 0.9955 | 418.65 ± 0.21 b |
| Hyal | 30 | 4.85 ± 0.09 cd | 0.45 ± 0.0 ab | 2.32 ± 0.0 bc | 0.9955 | 385.95 ± 0.92 b |
| Hyal/O3 | 1 | 6.35 ± 0.16 ab | 0.44 ± 0.00 ab | 2.57 ± 0.09 b | 0.9955 | 556.05 ± 21.28 a |
| Hyal/O3 | 15 | 5.59 ± 0.87 bc | 0.44 ± 0.03 ab | 1.63 ± 0.1 d | 0.9953 | 582.32 ± 42.49 a |
| Hyal/O3 | 30 | 4.11 ± 0.10 d | 0.48 ± 0.00 a | 1.33 ± 0.00 e | 0.9963 | 426.85 ± 8.56 b |
| Sample | Day of Measurement | Apparent Viscosity at Certain Shear Rates (Pa·s) | |||
|---|---|---|---|---|---|
| 10 s−1 | 100 s−1 | 200 s−1 | 300 s−1 | ||
| Hyal | 1 | 1.64 ± 0.03 a | 0.53 ± 0.01 a | 0.34 ± 0.00 a | 0.26 ± 0.00 a |
| Hyal | 15 | 1.32 ± 0.06 c | 0.45 ± 0.01 b | 0.30 ± 0.01 b | 0.23 ± 0.00 b |
| Hyal | 30 | 1.19 ± 0.01 d | 0.42 ± 0.00 c | 0.28 ± 0.00 c | 0.21 ± 0.00 c |
| Hyal/O3 | 1 | 1.51 ± 0.03 cd | 0.52 ± 0.01 a | 0.34 ± 0.01 a | 0.26 ± 0.00 a |
| Hyal/O3 | 15 | 1.24 ± 0.07 b | 0.46 ± 0.01 b | 0.30 ± 0.01 b | 0.23 ± 0.00 b |
| Hyal/O3 | 30 | 1.00 ± 0.03 e | 0.41 ± 0.01 c | 0.28 ± 0.00 c | 0.22 ± 0.00 c |
| Origin | ||||
|---|---|---|---|---|
| Species | Under Eyes | Cheeks | Hands | Total |
| S. aureus | 1 | 0 | 0 | 1 |
| S. haemolyticus | 1 | 1 | 2 | 4 |
| S. epidermidis | 1 | 0 | 1 | 2 |
| M. luteus | 2 | 6 | 2 | 10 |
| Total | 5 | 7 | 5 | 17 |
| Species | Origin | Hyal+O3 | C (Hyal) |
|---|---|---|---|
| S. aureus MSSA ATCC 29213 | type strain | 17 | 0 |
| S. aureus MRSA NCTC 12492 | type strain | 19 | 0 |
| M. luteus 1 | hands | 13 | 0 |
| M. luteus 2 | hands | 12 | 0 |
| A. viridans | hands | 14 | 0 |
| mean | 15.07 | ||
| Standard deviation | 3.01 | ||
| Coefficient of variation (%) | 19.99 | ||
| C. parapsilosis 1 | skin lesions | 8 | 0 |
| C. parapsilosis 2 | throat | 17 | 0 |
| C. albicans | mouth | 10 | 0 |
| C. guillermondii | eye | 9 | 0 |
| C. glabrata | vagina | 10 | 0 |
| mean | 10.93 | ||
| Standard deviation | 5.49 | ||
| Coefficient of variation (%) | 50.26 |
| Origin | ||||
|---|---|---|---|---|
| Species | Under Eyes | Cheeks | Hands | Type Species |
| Staphylococcus aureus | 2 | 2 | 2 | S. aureus MSSA ATCC 29213 S. aureus MRSA NCTC 12492 |
| S. haemolyticus | 2 | 5 | 3 | |
| S. epidermidis | 1 | 1 | 3 | |
| S. saprophyticus | 0 | 1 | 1 | |
| S. warneri | 0 | 1 | 0 | |
| S. cohnii | 0 | 0 | 1 | |
| S. pasteuri | 0 | 0 | 2 | |
| Micrococcus luteus | 5 | 7 | 5 | |
| Kocuria palustris | 0 | 1 | 1 | |
| Bacillus megaterium | 0 | 0 | 1 | |
| Aerococcus viridans | 0 | 0 | 1 | |
| Pseudomonas fulva | 0 | 0 | 1 | |
| Escherichia coli | 0 | 0 | 0 | E. coli ESBL+ |
| Total | 10 | 18 | 21 | 4 |
| Skin Lesions | Eye | Mouth/Throat/Tonsils | Vagina/Anus | Sputum | Type Species | |
|---|---|---|---|---|---|---|
| C. parapsilosis | 3 | 0 | 1 | 0 | 0 | Candida parapsilosis ATCC 22019 |
| C. albicans | 1 | 0 | 2 | 1 | 0 | Candida albicans ATCC 90028 |
| C. inconspicua | 1 | 0 | 2 | 1 | 0 | |
| C. guillermondii | 1 | 2 | 0 | 0 | 0 | |
| C. famata | 0 | 0 | 1 | 0 | 0 | |
| C. glabrata | 0 | 0 | 0 | 2 | 1 | |
| C. lusitaniae | 0 | 0 | 0 | 3 | 0 | |
| C. krusei | 0 | 0 | 0 | 2 | 1 | |
| C. lambica | 0 | 0 | 0 | 1 | 0 | |
| C. tropicalis | 0 | 0 | 1 | 0 | 0 | |
| C. kefir | 0 | 0 | 1 | 0 | 0 | |
| Total | 6 | 2 | 8 | 10 | 2 | 2 |
Publisher’s Note: MDPI stays neutral with regard to jurisdictional claims in published maps and institutional affiliations. |
© 2022 by the authors. Licensee MDPI, Basel, Switzerland. This article is an open access article distributed under the terms and conditions of the Creative Commons Attribution (CC BY) license (https://creativecommons.org/licenses/by/4.0/).
Share and Cite
Khachatryan, G.; Khachatryan, L.; Krystyjan, M.; Lenart-Boroń, A.; Krzan, M.; Kulik, K.; Białecka, A.; Grabacka, M.; Nowak, N.; Khachatryan, K. Preparation of Nano/Microcapsules of Ozonated Olive Oil in Hyaluronan Matrix and Analysis of Physicochemical and Microbiological (Biological) Properties of the Obtained Biocomposite. Int. J. Mol. Sci. 2022, 23, 14005. https://doi.org/10.3390/ijms232214005
Khachatryan G, Khachatryan L, Krystyjan M, Lenart-Boroń A, Krzan M, Kulik K, Białecka A, Grabacka M, Nowak N, Khachatryan K. Preparation of Nano/Microcapsules of Ozonated Olive Oil in Hyaluronan Matrix and Analysis of Physicochemical and Microbiological (Biological) Properties of the Obtained Biocomposite. International Journal of Molecular Sciences. 2022; 23(22):14005. https://doi.org/10.3390/ijms232214005
Chicago/Turabian StyleKhachatryan, Gohar, Lusine Khachatryan, Magdalena Krystyjan, Anna Lenart-Boroń, Marcel Krzan, Klaudia Kulik, Anna Białecka, Maja Grabacka, Nikola Nowak, and Karen Khachatryan. 2022. "Preparation of Nano/Microcapsules of Ozonated Olive Oil in Hyaluronan Matrix and Analysis of Physicochemical and Microbiological (Biological) Properties of the Obtained Biocomposite" International Journal of Molecular Sciences 23, no. 22: 14005. https://doi.org/10.3390/ijms232214005
APA StyleKhachatryan, G., Khachatryan, L., Krystyjan, M., Lenart-Boroń, A., Krzan, M., Kulik, K., Białecka, A., Grabacka, M., Nowak, N., & Khachatryan, K. (2022). Preparation of Nano/Microcapsules of Ozonated Olive Oil in Hyaluronan Matrix and Analysis of Physicochemical and Microbiological (Biological) Properties of the Obtained Biocomposite. International Journal of Molecular Sciences, 23(22), 14005. https://doi.org/10.3390/ijms232214005

